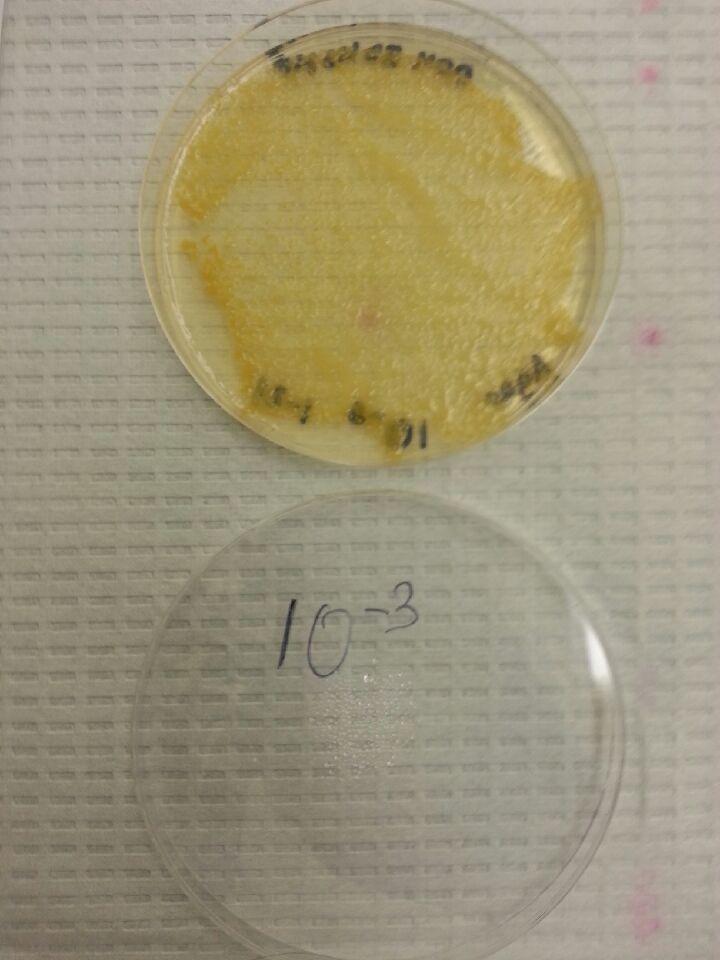
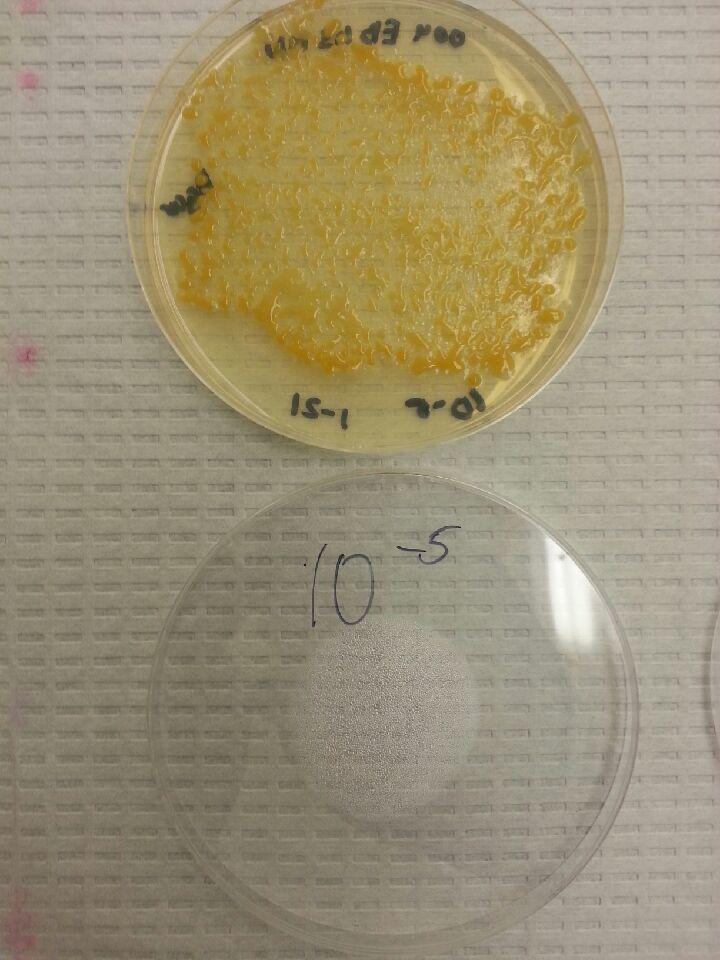
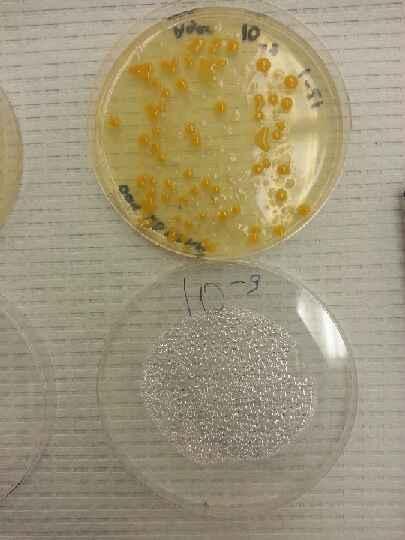

User:Medina Nurmanovs/Notebook/Biology 210 at AU
3/22/2015 MN Lab 6: Zebra Fish
Purpose: To observe the Rhodamine treatment effect on zebrafish embryos.
Materials and Methods: This experiment was held for two weeks and contained many different methods. To start the experiment, two Petri dishes were taken and labeled for Rhodamine treated and control groups. Dish for control group was filled with 20 mLs of Deer Park water. Unfortunately, the lab did not have a solution with required concentration of Rhodamine, so it was prepared by adding 1 mLs of Rhodamine to 19 mLs of Deer Park water. Then, 20 embryos were placed in each dish and looked at under a microscope. It turned out that all the embryos were moldy, and the experiment was started over a few says later. Each member of our group had to come in the laboratory on Friday, Monday or Wednesday and change solution/water in the dishes by removing 10 mLs and adding 25 mLs of solution/water, as well as removing all dead fish and recording everything in a table. On the second week, we started to feed the fish. Here is a list of data we recorded: -stage(hrs) -color -movement number of living & dead fish
Though the manual required measuring of things such as heart rate or yolk sack, it did not specify how to do it and we were not able to measure these.
One specimen was chosen from each dish and put into a tube with tricaine solution and para-formaldehyde. 
Due to skipping a cleaning day, only one embryo survived in treatment dish and it affected the results.
In the end of second week, all living zebrafish were put into two different containers: with treatment and controls.
Data and Observations: !!Somewhy I cannot attach pictures(except for the first one), OWW redirects me to a page with
Database error A database query syntax error has occurred. This may indicate a bug in the software. The last attempted database query was: REPLACE INTO `searchindex` (si_page,si_title,si_text) VALUES ('172595','--image-rhodamine stage png--',' ') from within function "SearchMySQL::update". MySQL returned error "126: Incorrect key file for table './owwdb/searchindex.MYI'; try to repair it (localhost)".
I know that it is not an excuse & will try my best to solve this, but it is already past deadline. Sorry.
Below are the recorded measurements of our zebrafish:
Conclusions and Future Directions:
Our group did not observe any changes in zebrafish other than slight color change. The treatment should have affected embryos in a way that makes them fluorescent, but is never was proven. 
The experiment almost failed because we were provided moldy zebra fish.
There were no clear instructions how to measure any of required measurements.
The skipped day did affect the experiment, however the survivor did not differ from the control group.
2/18/2015 MN
Lab 5: Invertebrates
Purpose: To observe the diversity of invertebrates that are found on the territory of our transect.
Materials and Methods: After taking the tube out from the Burlese Funnel that we constructed in the previous lab, we used two pipettes to take samples from the bottom and from the top of ethanol to put them into Petri dishes. Then we made wet mounts of the samples and look at them under dissection microscope. After finding an organism, we used dichotomous key and identified the organism. There also were insects in jars, which we looked at to see examples of symmetry and structure, a well as worms to see how their structure affects their movement.
Data and Observations: We identified five invertebrates with help of dichotomous key and calculated their sizes. Below is a table representing found organisms and photos of them.
There is not a lot of vertebrates present at this moment on the territory of our transect because of the winter season. But it is clear, that there are some organisms that live there in warmer times. For example, squirrels are present on the territory of whole campus, along with sparrows, rats and other small animals. They all depend on each other, as there is a small food web present on the transect. Berries/seeds -> Squirrels |
| -> bigger birds
invertebrates -> Birds |
All these organisms fight for food, especially when they are on the same trophic level, which means that they eat the same food. The amount of food can often put limits for number of animals of the same species that live on the same territory, and these limits are called carrying capacity. However, animals live in community which is stable.
Conclusions and Future Directions: This lab was held during winter season, thus there was not many insects on the territory of transect. However, those ones that we found show, that there is diversity in invertebrates and that some of them are not dormant during winter. They play a crucial role in community of the transect, being a food source for animals and birds.
References: Bentley, Meg. 2015. A Laboratory Manual to Accompany: General Biology II. Department of Biology, American University. 12-17. MN
2/11/2015 MN Lab 4: Plantae and Fungi
Purpose: To identify and study plant samples from the transect and observe fungi.
Materials and Methods: Lab consisted of three parts. 1. After visiting our transect and gathering 500 mg of leaf litter and samples of five plants, we returned to the laboratory and observed prepared slides under a microscope to see different structures of plants. To prepare cross sections of our samples, we used scalpels and razors, and then used the cross sections to make wet mounts. Then we looked at the wet mounts under microscopes to note their structure, size, color, as well as studied the samples to see vascularization. 2. Second part was to observe fungi under a microscope and identify their groups. 3. Third step was to collect invertebrates with a Berlese Funnel. We attached the funnel to a plastic tube, in which 25 ml of ethanol were poured. A piece of black net was placed and taped into the funnel to prevent leaves from falling into the tube. then we filled the funnel with leaves and placed it under a light. Then it was covered with aluminium foil.
Data and Observations: We took samples from five plants: 1) a medium tree, whose leave pattern was three leaves from one point, 2)tree with dead leaves, two kinds of monkey grass, 3)one of them with long and thin leaves and 4) another with short and thicker leaves, and, lastly, 5) from a purple plant with leaves growing from a central stem.
2.
3.
4.
5.
Here is a table representation of our observations.
We observed three types of fungi: agaricus bisporus, which belongs to basidiomycota gunfi because of structures that aloow the fungi to reproduce sexually, rhizopus stoloniger zygospore belongs to zygomycota as it can reproduce by creating zygospore, and rhizopus nigricons sporangia, which is a sugomycota as well.
Conclusions and Further Directions: We have studied only five plants out of many that are on our transect, and yet we can say that we observed diversity not only in appearance, but also in structure. All there plants co-exist on the territory of our transect.
MN
2/04/2015 MN Lab 3: Microbiology and Identifying Bacteria with DNA Sequences
Purpose: To observe bacteria that live in the soil of our transect and to understand how different concentrations of nutrient and antibiotic affect the growth of bacteria.
Materials and Methods: Firstly, we looked at our Hay Infusion that now has been there fr two weeks. It has reduced in volume and something has precipitated on the bottom. After that we moved on to studying Petri plates that we prepared on the last lab. We observed the connection between the amount of nutrient and antibiotics and counted the amount of bacteria colonies on each dish. Then we choose two dishes: the 10^(-9) nutrient plate and the 10^(-3) tet plate. With a metal loop we transferred some bacteria on slides and observed them under a microscope. It was hard, as bacteria was very tiny. After this we chose four dishes to create wet mounts for the next part of the lab: 10^(-3) and 10^(-9) from both tet and nutrient. To seal them on the slide we passed the slide over a burner for a few times. Then we put the slides on a dying bin and washed the wet mount with crystal violet die, iodine mordant, alcohol, and safranin stain. After each one we washed the slide with water. After this, we observed the slides under a microscope and determined if the bacteria is gram(+) or (-)(if it absorbs dye or not). After this, we took the same plates and started preparing PCR. To do this we put a sample of bacteria into 1000 ml water, incubated them for 10 minuted and put into a centrifuge for 5 minutes. This done, we added 1 ml water into each of 4 PCR tubes and transferred the supernatant from bacteria tubes into them. Them we gave the tubes to the TA.
Data and Observations: Here is the picture of our Hay Infusion:
The data that we collected by counting the number of colonies on the agar plates and photos of the plates. In the nutrient plated there were two types of bacteria: bright orange, which also was present on the tet plates, and clear. Probably, clear type of bacteria was killed by antibiotic ob the tet plates, however, the orange type was partially resistant to tet, as it appears even on plates with the highest concentration of it.
Nutrient Plates.
Tet plates.
The picture of 10^(-3) orange bacteria. It appeared white and curd-like.
10^(-9) bacteria under a microscope.
Pictures of the gram staining results.
10^(-3) nut.
10^(-9) nut.
10^(-3) tet.
10^(-9) tet.
Conclusions and Future Directions: Even though the amount of bacteria colonies differed between plates, one of the types of bacteria was resistant to the antibiotics and did appear on the tet plate with the highest concentration. Both of the bacteria are gram-positive, i.e. they absorb dye.
References: Bentley, Meg. 2015. A Laboratory Manual to Accompany: General Biology II. Department of Biology, American University. 12-17. MN
1/28/2015 MN
Lab 2: Identifying Algae and Protists
Purpose: To examine a soil sample, that was prepared in the previous lab. Understand that there are small ecosystems inside larger ones and learn how to recognize different protists under the microscope.
Materials and Methods: In the previous lab, me and my group prepared a Hay Infusion. To practice in identifying organisms, before preparing wet mounts of the infusion, we looked at wet mounts that were already placed on the microscopes and identified them with help of dichotomous key. After that, we started to work with the infusion. We took a few drops from the top of the liquid and from the bottom and placed them on pre-labeled separate plates. From each plate we prepared three wet mounts and added some Protoslow to slow down the protists. Each of us took a wet mount with organisms from top and bottom. Them we used microscopes to identify what protists live in the soil of our transect. Dichotomous key helped us to identify them.
Data and Observations:
Before working with of Hay Infusion, we smelled it, took photos and just look at it. It smelled like dirt and sewage. On top of the infusion appeared some kind of film. while the most of dirt settled on the bottom.
Unfortunately, we were not able to find three organisms in the top niche of the infusion, but we found four on the bottom. I think that the lack of organisms on top must have been caused by the film that grew on top. We tried to take a sample of it, but pipette was too small to take it. 
Here is the photo of a jar with our infusion, table representing organisms living in it.
Conclusions and Future Directions: Our hay infusion did not show a great diversity, perhaps because of the film that appeared on the top. But we were able to see organisms that appeared there only duting the week, so, in future, I suppose, it is possible to see more organisms, as they continue evolving and surviving.
M.N.
References: Bentley, Meg. 2015. A Laboratory Manual to Accompany: General Biology II. Department of Biology, American University. 12-17.
1/26/2015 MN
Lab 1: Biological Life at AU
Purpose: In this lab me and my group were assigned a transect on the territory of American University. Its name is Wildlife Habitat and it is situated just near the Hughes Hall. Our purpose was to carefully examine our transect and make an aerial-view map, as well as a list of all abiotic and biotic components of it. Also, a sample of soil was taken for later experiment.
Materials and Methods: Our group was not provided any special equipment for this lab. In the list of what we used was: a pencil, a notebook, a flashlight and a tube with collected soil. As the lab was held after the sunset, a flashlight was crucial for examining the transect, which consisted mainly of dirt, however, there were a few trees and rocks, as well as rick pathway. The soil was mixed with dead leaves and grass. Firstly, me and my group drew a map, then we started listing components of the transect. After this one of my classmates collected a sample of soil. As we did all this, we headed back to the laboratory to complete the second part of the lab: The Hay Infusion. It was an easy tack: all we had to do was to add 500 ml of water, 10-12 gm of soil sample and 0.1 gm f dry milk to a plastic jar, and then shake it. After this, we labeled the jar and its lid and placed open jar on a table in the laboratory.
Data and Observations: List of Biotic Components: trees bushes grass rat birds
List of Abiotic Components: snow rocks trash
Here is a map of the transect:
Conclusion and Future Directions: This lab was create to show us the diverse biological life at American University. Only in our 20 by 20 m transect me and my group have found many biotic and abiotic components. It was my mistake that I have not taken a photo of the transect, which I will do in the closest future.
M.N.
References: Bentley, Meg. 2015. A Laboratory Manual to Accompany: General Biology II. Department of Biology, American University. 12-17.